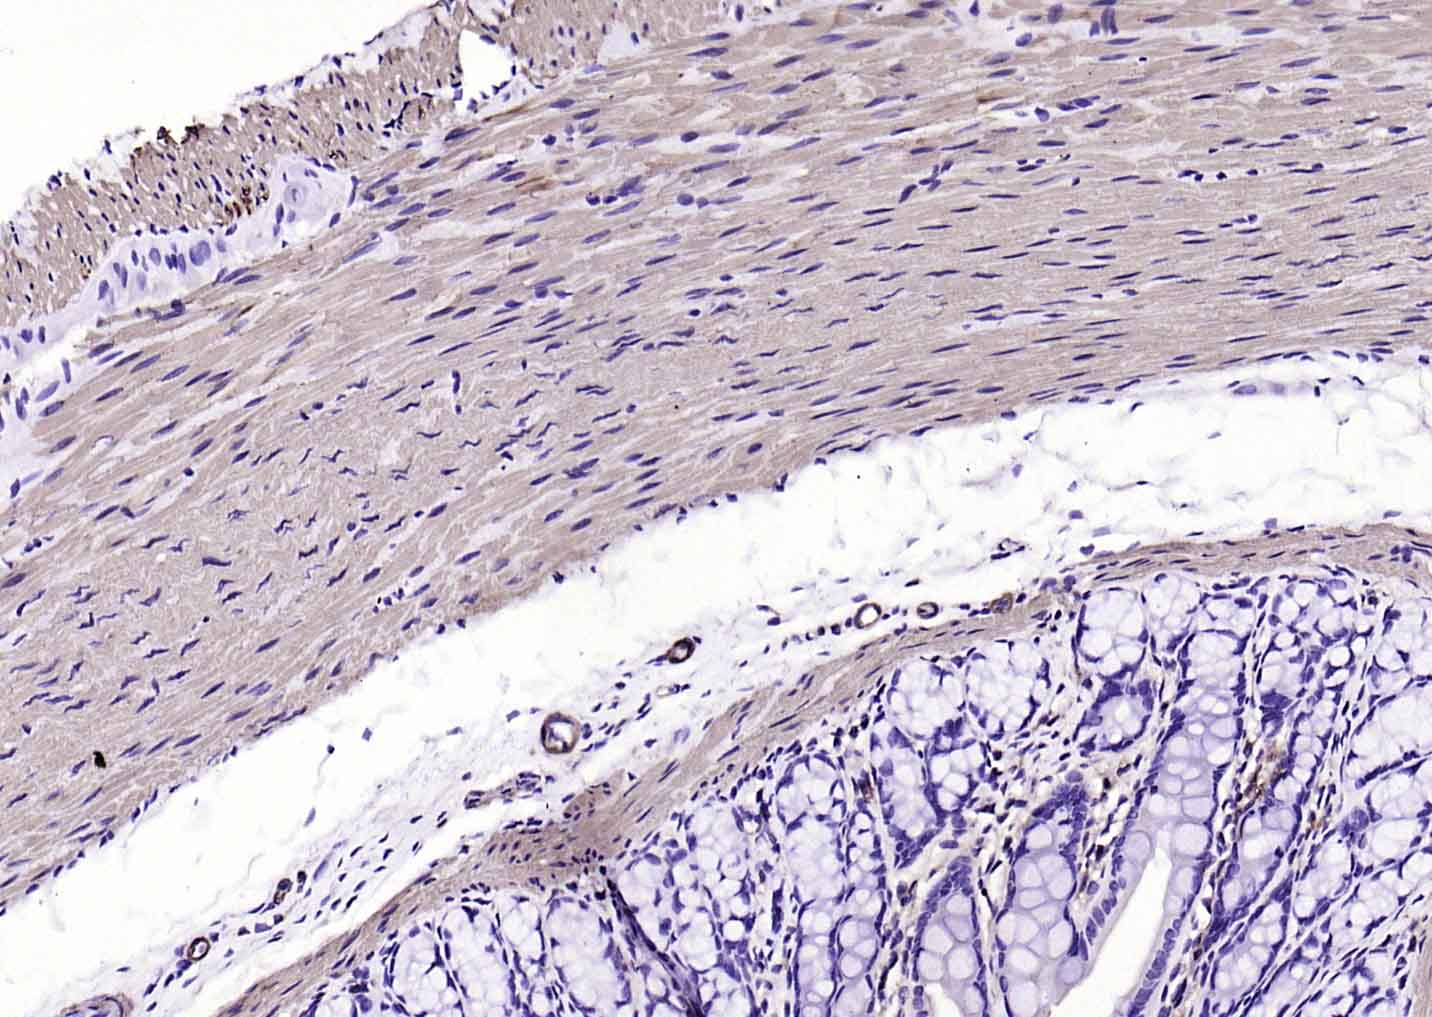
生物素标记的(ab)2片段羊抗小鼠IgG H&L

F(ab')₂ Fragment Goat Anti-Mouse IgG H&L, Biotin conjugated (标记二抗) | Bioss

货号:bs-60296G-Bio
产品详情
相关产品
相关文献
常见问题
概述
产品编号
bs-60296G-Bio
英文名称
F(ab')₂ Fragment Goat Anti-Mouse IgG H&L, Biotin conjugated
中文名称
生物素标记的(ab)2片段羊抗小鼠IgG H&L
英文别名
F(ab)2 Fragment Goat Anti-Mouse IgG H&L (Biotin); F(ab)2 Fragment Goat Anti-Mouse IgG H&L/Biotin; F(ab)2 Fragment Goat Anti-Mouse IgG(H+L)/Biotin;
标记
Biotin
抗体来源
Goat
免疫原
Native Mouse IgG
亚型
IgG
性状
Liquid
纯化方法
affinity purified by Protein G, nonspecific adsorbed
克隆类型
Polyclonal
储存液
10 mM TBS (pH=7.4) with 1% BSA, 0.02% Proclin300 and 50% Glycerol.
保存条件
Store at -20℃ for one year. Avoid repeated freeze/thaw cycles.
注意事项
This product as supplied is intended for research use only, not for use in human, therapeutic or diagnostic applications.
背景资料
Immunoglobulin G (IgG), is one of the most abundant proteins in serum with normal levels between 8-17 mg/mL in adult blood. IgG is important for our defence against microorganisms and the molecules are produced by B lymphocytes as a part of our adaptive immune response. The IgG molecule has two separate functions; to bind to the pathogen that elicited the response and to recruit other cells and molecules to destroy the antigen. The variability of the IgG pool is generated by somatic recombination and the number of specificities in an individual at a given time point is estimated to be 1011 variants.

产品应用
产品应用: WB=1:1000-20000, IHC-P=1:400-800, IHC-F=1:100-1000, IF=1:100-1000, Flow-Cyt=1:100-1000, ICC/IF=1:100-1000, ELISA=1:1000-20000
交叉反应
交叉反应: Mouse
相关产品
暂无相关产品